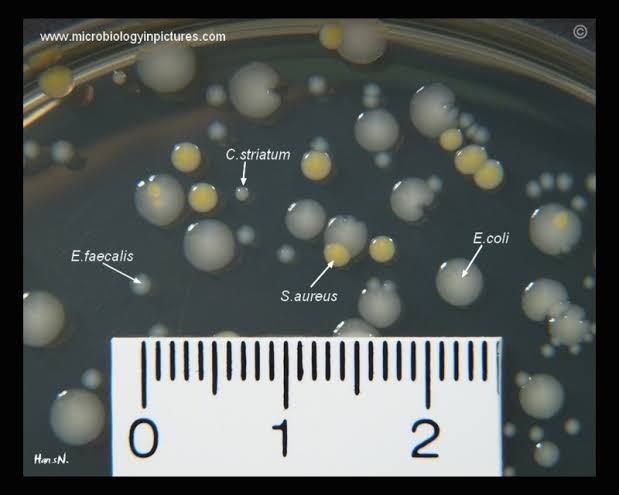
Article Image 2

With the onset of the summer season, when people flock to swimming pools around the world, the issue of the cleanliness of public swimming pools is once again in the spotlight. Swimmers are wondering just how clean the public pools are, bacteria and chemical irritants being a common concern, but what about parasitic outbreaks?

/*Chlorine is Not the Golden Bullet*/
Pools depend on chlorine and filtration to remain safe; however, according to the research, they are not fully safe. According to the 2013 review established by the CDC, a high of almost 60 % of tested public pools within metro-Atlanta were determined to have E. coli, an obvious evidence of fecal contamination. There also emerged parasites such as Cryptosporidium and Giardia, albeit not very commonly. And more recent statistics of Melbourne indicate that pools that tested with high bacterial levels, 160 and 120 cells per milliliter, at WaterMarc and PARC level, respectively, were above acceptable limits. During local crypto outbreaks, there were 87 cases reported in Victoria in 2025. Health officers recommended the exclusion of symptomatic individuals from using the pools for two weeks.
/*Widely Used Pollutants and their Associated Health effects*/
Bacteria like Staph aureus, enterococci, and E. coli usually get into the pools through the swimmer's skin contact, sweat, or even urine. Chlorine is effective in killing numerous pathogens, but it does not kill them instantaneously: the germs, such as Cryptosporidium, may survive its exposure, leading to the development of gastrointestinal illness for up to three weeks. Byproduct of chlorine and sweat or urine is chloramine, which can irritate the eyes, lungs, and skin. There are also viral outbreaks possible: since 1979, there have been more than 29 adenovirus-related outbreaks reported in pools in China, and the median cases per outbreak is 89 cases per outbreak

/*The reason problems persist*/
Most of the time, it is not chlorine but rather a lack of maintenance. Excessive bacteria were found even in the swimming pools, such as WaterMarc in Australia, which is accused of lapses in filtration or cleaning of water when the chemical standards are not met. Poor chlorine levels, insufficient filtration, excessive swimmer load, and non-regular maintenance records are the cause of 90 % of viral outbreaks in China. This is worsened by the fact that many operators inspect or fail to conduct testing regularly. There are existing habits, which are not unusual on the part of the swimmer, like skipping pre-swim showers and swimming with an illness, all of which increase the risk of contamination.

/*What You Can Do*/
Experts advise a multi‑layered approach:
/*1. Pre‑swim: */Take a shower, apply soap, and visit the toilet prior to being in the water.
/*2. No gulping water: */If the pool water enters the body, respiratory and gastrointestinal pathogens can easily transfer to others.
/*3. When sick, stay home: */The diarrhea ends, so avoid pools for 2 weeks.
/*4. Check inspections: */Most areas publish pool reviews before swimming; check them first.
/*5. Wash-up after a swim: */Wash out the chlorinated water, body fluids, and chemicals to save the skin and hair.

/*The Big Picture*/
Communal pools are of enormous benefit: health, recreation, and communal diversion. However, outbreaks of cryptosporidiosis (10,600 cases since 1997 in splash pads) and increasing numbers of bacteria detection support the vigilance. Operators should firm up the maintenance procedures and openness. Swimmers have to exercise responsibility; showering, avoiding polluted water, reading reports, and following rules. By being informed on both ends, the public will be able to keep their pools safe and fun throughout the year
